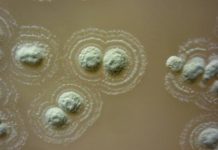
Research: New hope for tackling antibiotic resistance —

Research: Future technology for contactless medical procedures —
Surgeons won't be shrunk and sent into the body like in the 1960s Sci-Fi, Fantastic Voyage, but could program a specialised array of...
Research: Reliable tropical weather pattern to change in a warming climate —
Every month or two, a massive pulse of clouds, rainfall and wind moves eastward around the Earth near the equator, providing the tropics...
Research: An expanding bubble in an extra dimension —
Uppsala University researchers have devised a new model for the Universe -- one that may solve the enigma of dark energy. Their new...
Research: Marine debris study counts trash from Texas to Florida —
Trash, particularly plastic, in the ocean and along the shoreline is an economic, environmental, human health, and aesthetic problem causing serious challenges to...
Research: Trees’ ‘enemies’ help tropical forests maintain their biodiversity —
Scientists have long struggled to explain how tropical forests can maintain their staggering diversity of trees without having a handful of species take...
Research: Producers of white colonies on kimchi surface, mistaken as molds, have been identified...
WiKim (World Institute of Kimchi, General Director, Dr. Jaeho Ha) reported that the white colonies on the surface of kimchi is not formed...
Research: New hope for tackling antibiotic resistance —
Researchers analysing soil from Ireland long thought to have medicinal properties have discovered that it contains a previously unknown strain of bacteria which...
Research: Amber preserving newborns, egg shells, and egg bursters shows that the hatching mechanism...
Fossilised newborns, egg shells, and egg bursters preserved together in amber provide the first direct evidence of how insects hatched in deep time,...
Research: Droughts boost emissions as hydropower dries up —
When hydropower runs low in a drought, western states tend to ramp up power generation -- and emissions -- from fossil fuels. According...
Research: Declining water levels in the Great Salt Lake contribute to snowmelt —
Utah's Wasatch Mountains are famous for having "The Greatest Snow on Earth." Snow-seekers in pursuit of world-class skiing and snowboarding contribute over a...
Top News
Hey ISIS, You Suck: Local Muslims Post Anti-ISIS Billboard
A new billboard on Manchester Road in Missouri reads, "HEY ISIS, YOU SUCK!!! From: #ActualMuslims."
A group of Muslim-Americans have put up a blunt billboard...